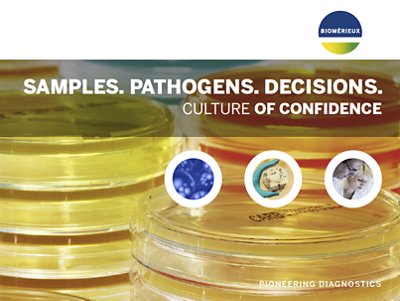

Health Risks and Outcomes of Congenital and Perinatal Infections
Some maternal infections contracted before or during pregnancy can be transmitted to the fetus, during gestation (congenital infection), or during labor and childbirth (perinatal infection). Viral and bacterial infections during pregnancy can pose serious health risks for the fetus, such as spontaneous abortion, premature birth, stillbirth, intrauterine growth restriction, and fetal neurological defects.1
One of the most prevalent causes of neonatal infections is Group B Streptococci (Streptococcus agalactiae) – linked to over half a million preterm births, 100,000 newborn deaths, and 46,000 still births annually.2 Due to the high prevalence of GBS infection (1 in 4 women carry GBS bacteria in their body), the CDC as well as various local guidelines recommend and promote universal GBS screening to minimize the risk of transmission.3 GBS screening in medical labs with prenatal care or maternity wards is critical for better patient outcomes. Accurate GBS detection is necessary to implement the appropriate precautionary measures to reduce the risks of neonatal infection. According to the CDC, it is recommended that all pregnant women get a GBS test conducted when they are 35–37 weeks pregnant.3
Other infections that must be monitored throughout pregnancy include screening for Toxoplasmosis, Rubella, and Cytomegalovirus (ToRC). If women are infected during pregnancy, consequences for the fetus can be severe.
What is Our Solution for Congenital and Perinatal Infections?
The clinical microbiology laboratory plays a critical role in screening for and detecting congenital and perinatal infections.
Our solutions include:
- CHROMID® Strepto B, a selective chromogenic medium for the screening of Group B Streptococci, provides increased recovery with specific coloration, including beta-hemolytic and non-hemolytic bacteria. Additional benefits include the inhibition of many contaminants that can help to streamline workflows by limiting unnecessary tests. CHROMID® Strepto B results are also easy to read and easy to implement within the laboratory.
- VIDAS® ToRC Panel, a complete solution for diagnosing and monitoring the most important materno-fetal infections in pregnant women and newborns. Toxoplasmosis, Rubella, and Cytomegalovirus (ToRC) infections are generally benign diseases. However, when women are infected during pregnancy, consequences for the fetus can be dramatic. Our value-added IgG avidity tests help distinguish between recent and past infections, thus reducing the number of amniocenteses, and avoiding unnecessary treatment and stress for the future mothers.
- IgG: IgGs are widely used to determine the presence of specific immunity.
- IgM: If IgMs appear earlier than IgGs, they also disappear earlier. This makes IgMs an early and sensitive marker of acute infection.
- IgG avidity: IgGs are initially of low avidity but will mature to high avidity a few months after primary infection. A high IgG avidity index thus allows to rule out recently acquired infection. Our value-added IgG avidity tests help distinguish between recent and past infections, reducing the number of amniocenteses, and avoiding unnecessary treatment and stress for future mothers.
- IgG: IgGs are widely used to determine the presence of specific immunity.
WASPLab®, WASP®, and PhenoMATRIX®: CHROMID® Strepto B provides flexibility with the option for manual or automated workflows when combined with WASP®/WASPLab® and PhenoMATRIX® color detection interpretation algorithms.
VITEK® MS and VITEK® 2: A unique Certificate of compatibility assures the use of the tested plates with the VITEK® MS and VITEK® 2 for identification as well as for Antimicrobial Susceptibility Testing (AST). bioMérieux guarantees the use of CHROMID® Strepto B with the VITEK® range.
Disclaimer: Product availability varies by country. Please consult your local bioMérieux representative for product availability in your country.
Congenital and Perinatal Infections – Our Diagnostic Offer
-
Chromogenic & High Medical Value Media
Patented chromogenic media for rapid, reliable culture & identification
The innovative and extensive CHROMID® range of chromogenic media is the easy way to rapidly and reliably detect and identify microorganisms for faster/direct ID of pathogens and MDRO. The intensity and specificity of the colors of CHROMID® make identification and results clear to see, even with mixed cultures .
-
VIDAS® ToRC Panel
Serenity throughout Pregnancy
The VIDAS® ToRC panel includes 9 automated tests for the screening and diagnosis of toxoplasmosis, rubella, and cytomegalovirus (CMV) infections.
Useful Resources on Congenital and Perinatal Infections
CHROMID® Strepto B Tutorial Video
References
1Jash S, Sharma S. Pathogenic Infections during Pregnancy and the Consequences for Fetal Brain Development. Pathogens. 2022;11(2):193. doi: https://doi.org/10.3390/pathogens11020193
2Urgent need for vaccine to prevent deadly Group B streptococcus. www.who.int. https://www.who.int/news/item/02-11-2021-urgent-need-for-vaccine-to-prevent-deadly-group-b-streptococcus
3GBS. Published 2020. https://www.cdc.gov/groupbstrep/about/fast-facts.html